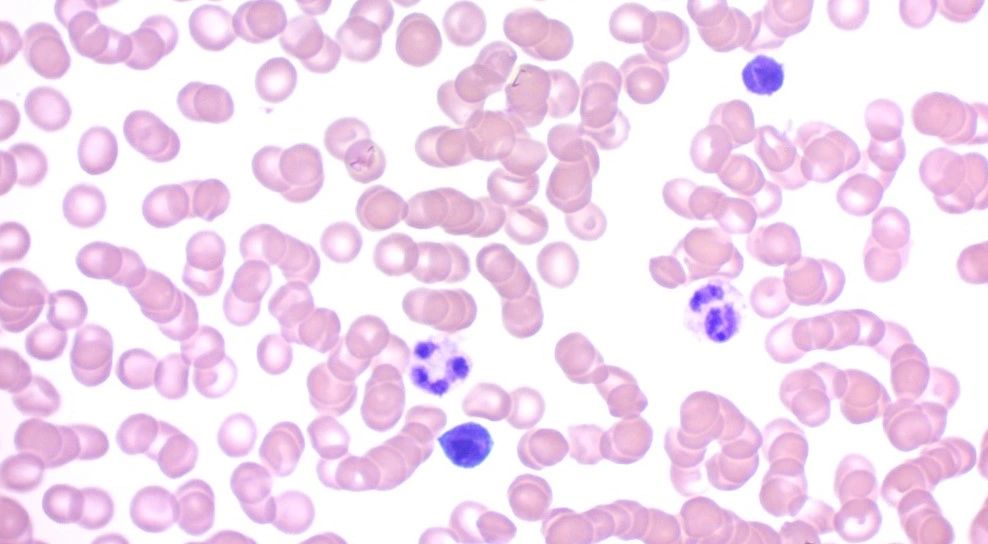

Category: Science,
Platform: GoDaddy Online Store
Technologies used: Cloudfront CDN, Google Adsense, Google Analytics 4, Google Tag Manager
Signup for Free. No Credit Card required.Suitable for marketing agencies, app developers and new business ideas.
No credit card required.